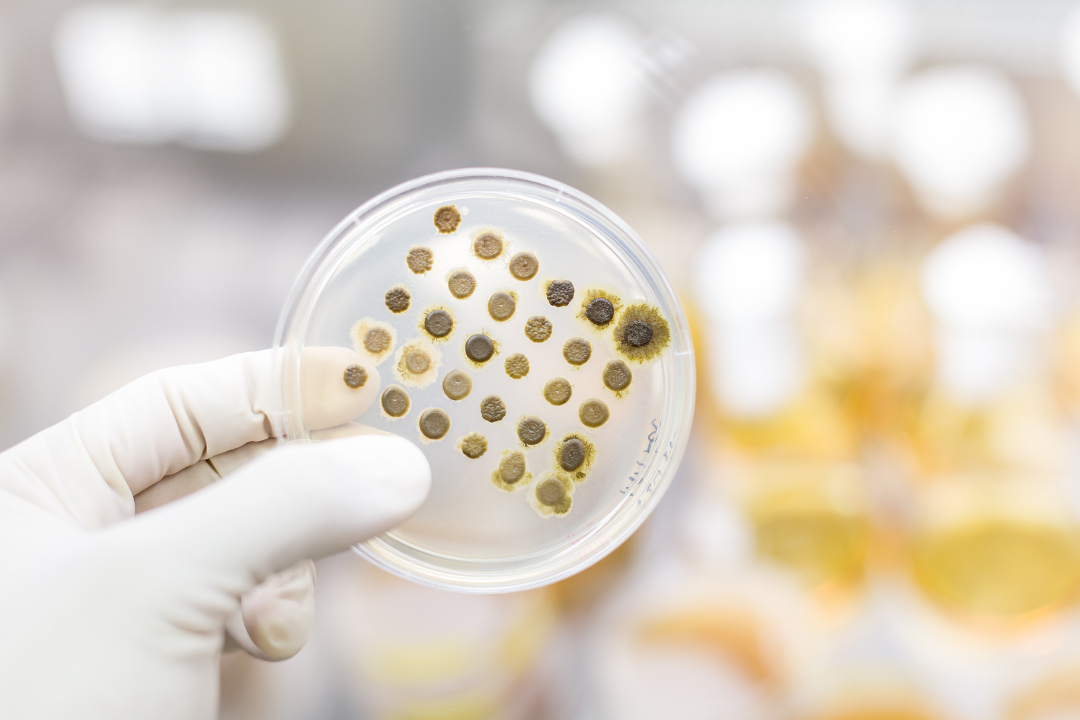
未命名__2023-04-24+16_29_25.png

油脂制品类保健食品因其独特的营养价值深受消费者的喜爱,被誉为“液体黄金”。随着全球健康消费升级,油脂制品类保健食品呈现出多元化的趋势,种类日益丰富。下面,小编带大家了解一下油脂制品类保健食品的海关归类。
一、单一成分制品
01 鱼肝油
80、90后的小伙伴应该大都吃过鱼肝油,对这种略带腥味的黄色液体印象深刻。鱼肝油提取自鱼的肝脏,富含维生素A、维生素D,可以防治夜盲症、小儿佝偻症等,是最常见的保健品之一。早在1950年我国就建立了第一家鱼肝油厂,从此,鱼肝油走进千家万户,成为一代中国人难忘的童年回忆。
鱼肝油是税则具体列名的商品,根据归类总规则一、六,鱼肝油应归入税则号列 1504.1000。
02 鱼油
鱼油与鱼肝油名字虽然相似,但成分截然不同。鱼油自鱼类脂肪提取而成,主要成分是 Omega-3脂肪酸。Omega-3是一组多元不饱和脂肪酸的统称,其中最典型的两种成分是二十碳五烯酸(EPA)和二十二碳六烯酸(DHA),对人体有扩张血管、抑制凝血、促进脑细胞发育等诸多益处。
鱼油是税则具体列名的商品,根据归类总规则一、六,鱼油应归入税则号列 1504.2000。
03 藻油
藻油是从寇氏隐甲藻、裂壶藻、吾肯氏壶藻等海洋藻类中萃取出的浓缩油脂,和富含 EPA 和DHA、且 EPA含量往往更高一些的鱼油不同的是,藻油中对人体有益的营养成分以DHA为主。
根据归类总规则一、六,藻油应按微生物油、脂及其分离品归入税则号列 1515.6000。
04 磷虾油
磷虾油主要提取自南极磷虾,其同样含有 EPA 和 DHA,但两者的含量通常都要低于鱼油。不过,磷虾油中另外还含有虾青素,同样对人体颇有益处。
根据归类总规则一、六,藻油应按微生物油、脂及其分离品归入税则号列 1515.6000。
对于以上归入15.04、15.06、15.15等税则15章的各类单一成分的产品,参考海关总署 J2006-0003号归类决定,可出于安全或保存等需要添加微量的抗氧剂、稳定剂等物质,但所添加的物质不得改变产品一般用途。
二、混合成分制品
(一)15.17税目商品
除了上述单一成分的油脂制品外,混合油脂制品也较为常见。根据税则品目注释,各种动、植物或微生物油脂的混合物应归入税目15.17,这些混合物中也可添加少量的色素、香料、维生素等。
以海关总署Z2022-0010号归类决定提到的“贝蒂喜DHA饮料”为例,其以葵花油、DHA 藻油、小麦胚芽油为主要成分,另外加入少量柠檬汁和橙汁以调节风味。
由于该商品属于混合油脂制品,所添加的少量调味物质并未改变其基本特征,故根据归类总规则一、六,应按混合制成的油脂制品归入税则号列 1517.9090。
(二)其他税目商品
一般而言,混合油脂制品应优先考虑税目15.17。但由于税目15.17对可添加的物质有明确规定,如果添加物超出了税目15.17所允许的范畴,则应考虑其他税目。例如某品牌的“藻油DHA胶囊”,其胶囊内容物的主要成分为藻油63%、中链甘油三酯15%、甜橙油9%、神经酸3%等。由于成分“神经酸”和“甜橙油”均超出税目15.17所允许添加的商品范围,故不能再按照混合油脂制品归入税目15.17。根据归类总规则一、六,此商品应按其他品目未列名食品归入税则号列 2106.9090。
另外,有些商品虽然所含油脂成分单一,但由于所添加的其他物质较为复杂,此时应考虑归入除15章以外其他章节的可能。以某品牌的“鱼油软糖”为例,其外观为软性糖果,其主要成分为鱼油33%、木糖醇27%、水18%、山梨糖醇12%、明胶7%等。需要注意的是,商品的甜味来源并非真正的糖,而是合成甜味剂木糖醇。此商品所添加的物质超出了15章允许的范围,而根据税目 17.04的排他条款,这种“不含糖”的鱼油软糖也不属于17.04所称的糖食,故根据归类总规则一、六,应按其他品目未列名食品归入税则号列 2106.9090。
来源:阿拉甬关
小贴士
亚洲码欧美码一区二区三区-99热这里只有精品8-国产偷2018在线观看午夜-入室强伦女教师在线播放-两男一女一床一添一摸拥有区内区外七个报关网点,为海陆空进出口提供报关报检服务,是海关高级认证的AEO企业,蝉联六届全国优秀报关行称号,是海关预归类服务单位。公司拥有加工贸易、预归类、减免税、产地证、税证调研、关务策划专员、关(检)务师等专业技术人员近60人。
商务中心 Amoly 陈经理
TEL:0592-5608333-118/19859176643(微信同号)
Email:[email protected]


